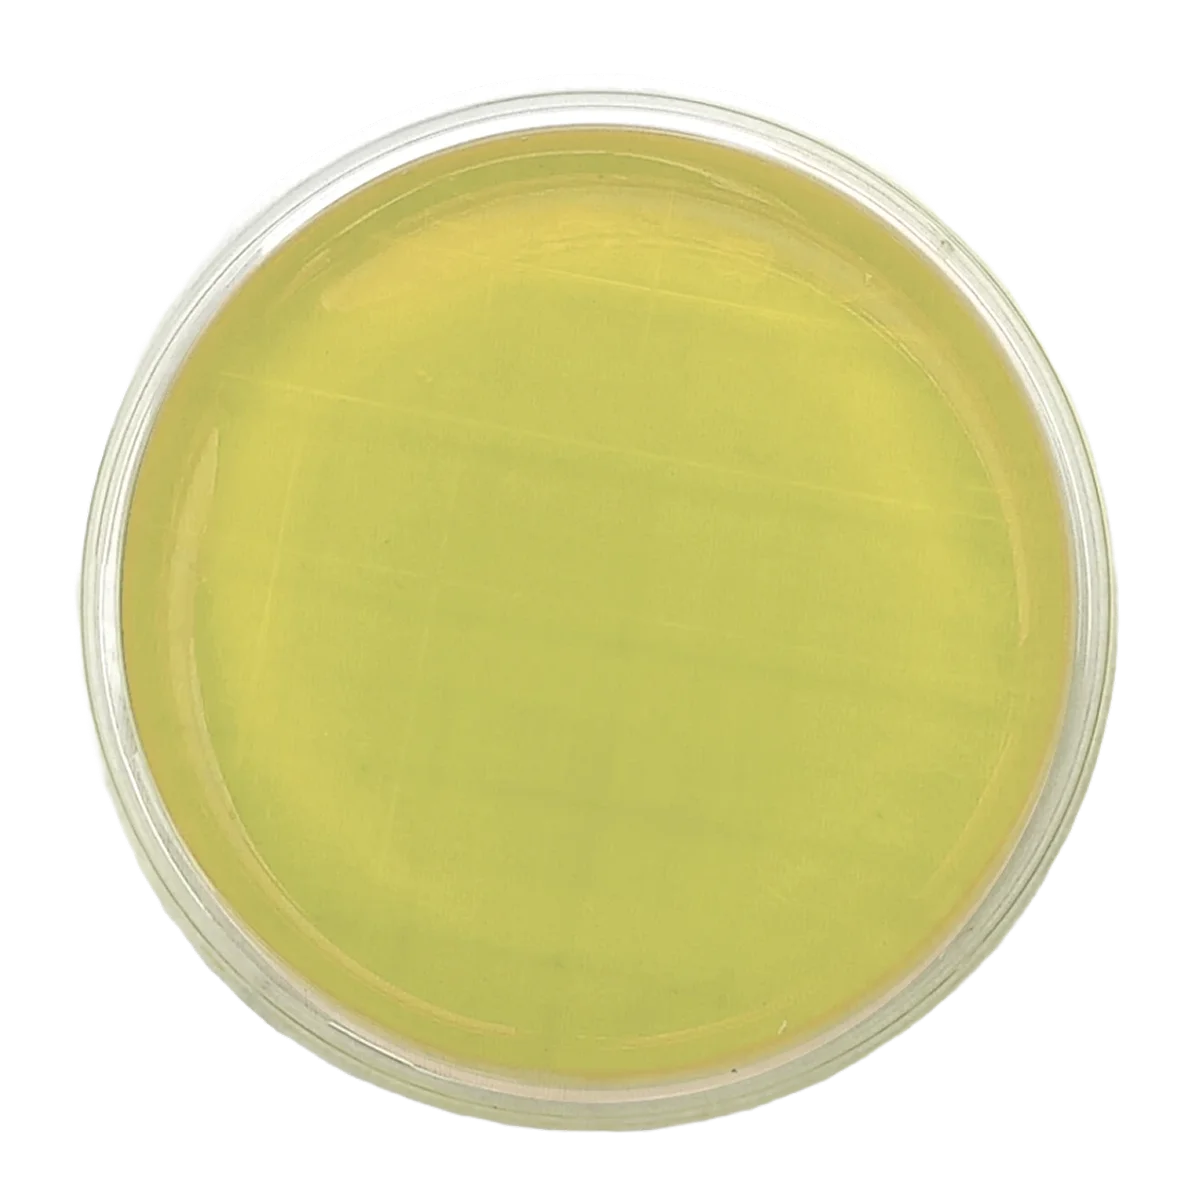

AGAR DIGERIDO CASEINA Y SOJA (TSA) + LECITINA +POLISORBATO + TIOSULFATO + L-HISTIDINA +PENASE – Irradiado – Placa tipo Rodac Ø 65 mm.
Nº DE CATÁLOGO: MKB-65SCDATLHTh-P
Precio sin IVA
Medio sódilo de cultivo general que contiene peptona animal y de soja y neutralizantes, de acuerdo a la Farmacopea Harmonizada.
Presentación: Placa tipo Rodac Ø 65 mm. Caja x 10 placas Marca MIKROBIOL.
FECHA ESTIMADA DE ENTREGA: 15 - 20 días
| Industria | Regulaciones | Composición (g/l): |
| Control AmbientalCosméticaFarmacéutica/Veterinaria | Farmacopea EuropeaUSP | Armonizado Según USP/BP/JPPeptona de caseína........................15,00 gPeptona de soja..............................5,00 gCloruro Sódico.................................5,00 gPolisorbato 80.................................5,00 gLecitina...........................................0,70 gTiosulfato de Sodio.........................5,00 gL-Histidina…..................................1,00 gPenicilinasa….................................10,00 mlAgar.................................................15,00 g |
Descargar ebook
Por favor complete el formulario y seleccione en la lista el ebook a descargar

CONTÁCTENOS
Argentina:
Buenos Aires. Argentina
Sargento Cabral 2431
Vicente López
CP 1605
Tel: +54 9 11 3027-3162
LATAM
Asunción, Paraguay
Misiones 593 e/ Perú
CP 1102
Tel : +57 310 4594786
EEUU:
Florida. EEUU
1101 Brickell Avenue South, Tower 8th Floor, Miami,
FL 33131
Tel: (305) 381- 1855
Asesoramiento y ventas:
ventas@mikrobiol.com